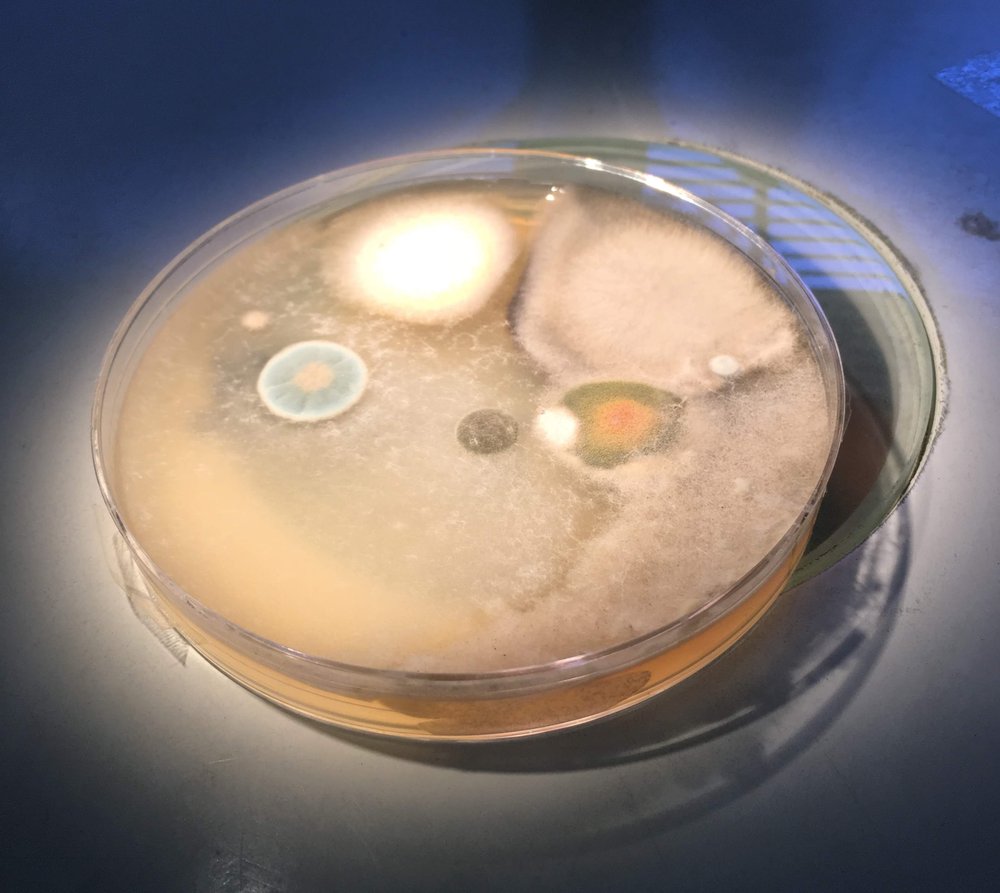
AG Environmental Solutions - mold inspector in Boca Raton, FL

AG Environmental Solutions
Mold Inspector in Boca Raton, Florida
About AG Environmental Solutions
Boca Raton residents looking for environmental testing have AG Environmental Solutions at 20581 Carousel Cir W. They do not have Yelp reviews posted yet. They are listed under environmental testing. Florida's large retiree population drives strong demand for local regulations.
How They Can Help
Services at AG Environmental Solutions include environmental testing. Environmental testing and mold inspection tell you what is actually in your air and walls, which matters more than guessing. Call (954) 736-7441 to schedule.
What to Expect
Call (954) 736-7441 to schedule an inspection. The inspector will walk the property with a moisture meter, check problem areas, and collect air or surface samples if needed. Lab results typically come back within 2 to 5 business days.
Service Area
AG Environmental Solutions is at 20581 Carousel Cir W in Boca Raton, FL. They serve the local area and surrounding communities.
Frequently Asked Questions
Does AG Environmental Solutions do remediation too?
Is mold testing necessary or can I just see it?
How long does a mold inspection take?
Does homeowners insurance cover mold?
Need a Cleaner Mold Case File?
MoldLedger helps homeowners and pros keep intake, photos, findings, and next steps in one clean case record.
Start a Case